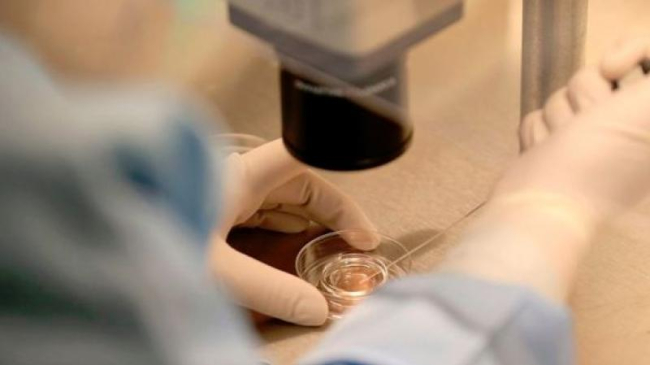
mamaplus.md

Cercetătorii chinezi au creat în laborator primii bebeluși modificați genetic, ceea ce va marca un „înainte” și un „după” privind conceperea.

O echipă de oameni de știință din China susține că a creat primii copii modificați genetic. Este vorba despre două fetițe gemene născute la începutul acestei luni, ale căror gene au fost modificate pentru a rezista la o posibilă infectare cu virusul HIV, notează BBC News.
Cercetătorii au alterat embrionii a șapte cupluri însă doar doi au supraviețuit modificării genomului. Chiar și așa, este o realizare istorică pentru lumea geneticii, cea mai importantă după clonarea oiței Dolly.
Majoritatea experților în genetică refuză această idee ca fiind una de viitor și nu achesează la astfel de tehnici din motive etice.
În Statele Unite, de exemplu, modificările genetice sunt interzise, iar în Europa la fel. Cercetătorii americani se tem că genele modificate pot da peste cap generații întregi pentru că se vor transmite de la o persoană la alta, iar asta poate reprezenta un precedent periculos.
Sursa: teotrandafir.com